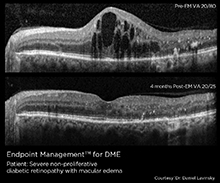

ENDPOİNT MANAGEMENT:LAZER TERAPİNİN YENİDEN TANIMLANMASI
Endpoint Management(EpM), foto-stimülasyon yöntemi ile RPE’yi seçici olarak uyaran fototerapi uyarımı kullanır. EpM kullanarak, kesin olarak gücü düşürebilir ve özellikle RPE hücrelerini etkiler.
EpM, lazer gücünü zor yanıklara kadar titreterek başlar, ardından hekim tedavi alanlarına iletilecek enerjinin yüzdesini seçer. Landmark Pattern, tedavi edilen bölgenin görünür göstergelerini sağlar.
EpM, maküler tedavi ve PRP için 532 nm veya 577 nm lazer dalga boylu PASCAL lazerler için kullanılabilir.
GLOKOM İÇİN PSLT ( PATTERN LASER TRABEKULOPLASTİ ™)
PASCAL sistemlerinin tarama teknolojisi ve hassasiyeti, lazer trabeküroplasti için doku koruyucu bir lazer tedavi etme modalitesi kullanmaktadır.
Şekil taramalı Lazer Trabeküloplasti (PSLT) * desenlerin hızlı, hassas ve minimal travmatik (görünmez) bilgisayar destekli tedavi sağlar.
Desenler, diğer laser modalitelerine kıyasla daha hızlı ve daha kolay uygulamalar sağlayan trabeküler ağ örgüsüne(meshwork) kolayca hizalanır.
Doktorlar, şimdi PSLT ile glokom yönetiminde PASCAL lazerlerini kullanabilir.
Avantajları açık:
Bilgisayar destekli tedavi
Zarar vermeyen prosedür
Klinik olarak etkili
Tekrar Tedavi etme imkanı

PASCAL TEKNOLOJİSİ
PASCAL, dünyadaki ilk lazer tarama lazeri olmakla birlikte, aynı zamanda desen tarama için en uygun tasarımı da içeriyor.
